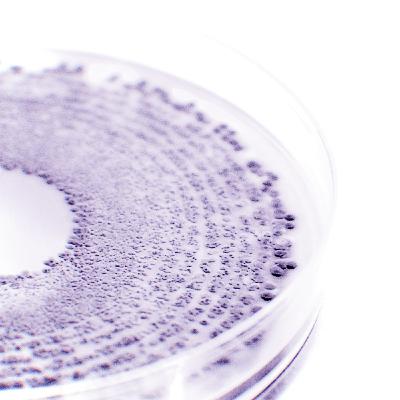

Active Beauty on air by Givaudan
Subscribed: 1Played: 1
Subscribe
© Melanie Pelican
Description
Discover on this new podcast channel our world as a creator of high-end cosmetic ingredients that make people look and feel good. Together we will explore some market trends and delve into our innovative and powerful molecules that are backed by strong scientific recognition, high naturality and consumer awareness.
Stay tuned for more new stories from Givaudan Active Beauty as we reinvent our industry to offer the best of Beauty!
Don't forget to follow us on Instagram (https://www.instagram.com/givaudanbeauty/)
Hosted by Ausha. See ausha.co/privacy-policy for more information.
Stay tuned for more new stories from Givaudan Active Beauty as we reinvent our industry to offer the best of Beauty!
Don't forget to follow us on Instagram (https://www.instagram.com/givaudanbeauty/)
Hosted by Ausha. See ausha.co/privacy-policy for more information.
3 Episodes
Reverse
Comments